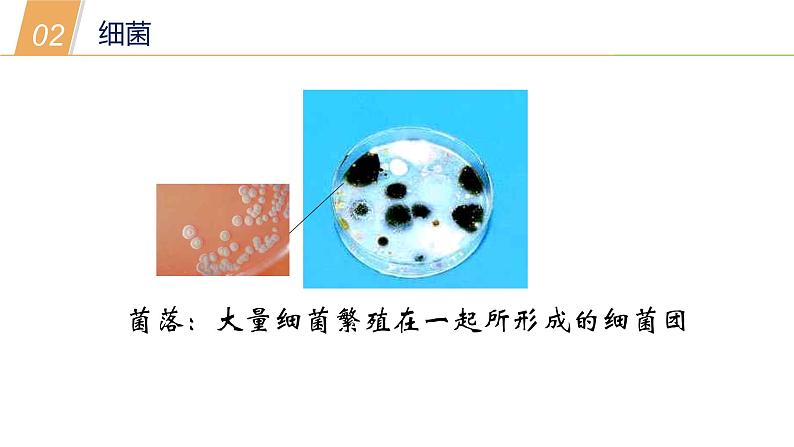
2.3细菌和真菌—华东师大版七年级科学上册课件08

华师大版七年级上册3 细菌和真菌备课ppt课件
展开思考:动植物的本质区别是什么?
营养方式不同,动物---异养,植物---自养
阅读课本P58前言,思考以下问题:
2.细菌和真菌怎么生存?
3.细菌和真菌和我们有什么关系?
细菌的结构特点:细菌约有2000多种,个体十分微小(直径大多0.5~2.0微米),分布极其广泛。细菌无成形的_______。细菌的形状有_____、_____、______。
观察课本P58图2.3.1,感受细菌的大小
菌落:大量细菌繁殖在一起所形成的细菌团
细菌的营养方式:多数细菌体内没有_______,不能自己制造________。
细菌的营养方式可以分成两类——异养和自养。多数的细菌是进行异养的,少数的细菌是进行自养的。
细菌对我们来说是有益还是有害?
(是大自然_________的主要参与者)
分解动植物尸体,把有机物变成无机物。
人体内有有益于健康的细菌
根瘤菌——豆科作物固定氮
乳酸杆菌——制酸奶、泡菜
大肠杆菌——合成维生素
醋酸杆菌——制作食用醋
能分解动植物的尸体,把有机物变为无机物,在自然界的物质循环中起重要作用
结核杆菌---引起的结核病
痢疾杆菌---典型细菌性痢疾
肺炎双球菌---引起大叶性肺炎
思考:如何更好的保存食物?
真菌的结构特点:真菌的种类繁多,形态、大小各异。有的是单细胞的,如酵母菌,大部分是多细胞的真菌。真菌有成形的______ 。
真菌的营养方式:真菌不能自己制造 ,必须依靠现成的有机物维持生活,营养方式属于 ,在自然界的物质循环中起重要作用。
分解动植物尸体(把有机物变成无机物),……
农作物病害,人得甲癣和脚癣。
酵母菌 用来酿酒、面包馒头的发酵
食用菌 (可以食用的真菌) 蘑菇、木耳、灵芝 这是些大型的真菌,但有些大型真菌有毒。
曲霉 花生的黄曲霉素,生产酱和酱油
1.许多食品的制作都要利用细菌和真菌,下列可用于制造啤酒的是( )A.酵母菌 B.青霉菌C.醋酸菌 D.乳酸菌
2.下列关于微生物的叙述中正确的是( )A.霉菌都是对人体不利的,如黄曲霉产生的黄曲霉毒素可能致癌B.细菌是单细胞个体,细胞内有成形的细胞核C.春天可以到野外采食真菌,野外的真菌鲜美,可以随意食用D.蘑菇和腐生细菌一样,能分解枯枝败叶,有利于自然界中的物质循环
3.美国遭受“9·11”恐怖袭击后,国内出现“炭疽”传染病,引起这种病的病原体是一种叫炭疽杆菌的生物。已知这种生物仅由一个细胞构成,没有成形的细胞核,其属于哪一类生物( )A.细菌 B.真菌C.植物 D.动物
4.夏天的时候,受潮的面包、衣物和皮鞋容易发霉长毛,请问这些霉菌是从哪来的( )A.人为放上去的B.来自空气C.物品中的某些物质变来的D.因为有这些物品,它们感应而来的
5.下列不属于细菌的是( )A.乳酸杆菌 B.香菇C.大肠杆菌 D.葡萄球菌
6.下列环境中最容易生长细菌、真菌的是( )A.潮湿的沙土 B.干燥的衣服C.新鲜的桔皮 D.罐装的奶粉
7.下列有关细菌和真菌在生产实践中的应用正确的是( )A.醋酸菌——酸奶 B.大肠杆菌——沼气C.霉菌——泡菜 D.酵母菌——馒头【解析】 酸奶是以鲜牛奶为原料,加入乳酸菌发酵而成。在生活污水和工业废水中有很多有机物,可以作为细菌的食物,在无氧的环境中,一些杆菌和甲烷菌等细菌通过发酵把这些物质分解,产生甲烷(沼气)。制作泡菜用到乳酸菌。做馒头或面包时,经常要用到酵母菌,酵母菌可以分解面粉中的葡萄糖,产生二氧化碳。
8.人们常说“菌从手来,病从口入”,是因为人们手上分布着大量微生物。图中所示为无菌固体培养基经人手按压,培养一段时间后菌落生长的结果,下列相关叙述不正确的是( )A.手上可能既有细菌又有真菌B.细菌、真菌在自然界广泛分布C.用清水洗手可起到灭菌作用D.手上的微生物不都对人体有害
初中科学浙教版七年级下册第1章 代代相传的生命第6节 细菌和真菌的繁殖教案配套课件ppt: 这是一份初中科学浙教版七年级下册<a href="/kx/tb_c77613_t3/?tag_id=26" target="_blank">第1章 代代相传的生命第6节 细菌和真菌的繁殖教案配套课件ppt</a>,共39页。PPT课件主要包含了引入新课,学习目标,螺旋菌,细菌的结构,细菌的生殖分裂生殖,显微镜下的酵母菌,酵母菌的出芽生殖过程,青霉孢子,曲霉孢子,蘑菇的生殖等内容,欢迎下载使用。
初中科学华师大版七年级上册3 细菌和真菌课文课件ppt: 这是一份初中科学华师大版七年级上册3 细菌和真菌课文课件ppt,共17页。PPT课件主要包含了依赖现存的有机物生活,细胞分裂,螺旋菌,食物的腐败,肺炎双球菌,炭疽杆菌,结核杆菌,各种疾病,根毛细胞上的根瘤菌,乳酸菌等内容,欢迎下载使用。
科学七年级上册3 细菌和真菌课堂教学ppt课件: 这是一份科学七年级上册3 细菌和真菌课堂教学ppt课件,共22页。PPT课件主要包含了分布广泛的细菌和真菌,谢谢指导,大肠杆菌细菌,①球菌,②杆菌,③螺旋菌等内容,欢迎下载使用。














